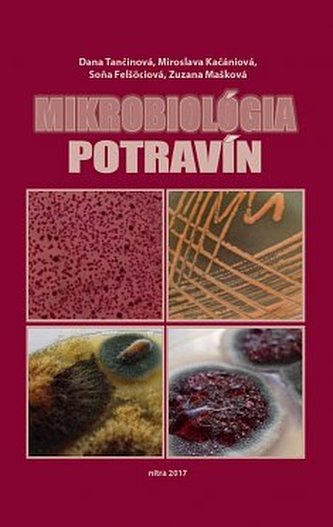
Mikrobiológia potravín

Mikrobiológia potravín
18,52
€
Cena nižšia o 3 % oproti DMOC
Obsah:
1.Mikroorganizmy dôležité v potravinárstve
2.Faktory ovplyvňujúce rast mikroorganizmov v potravinách
3.Kontrola mikroorganizmov v potravinách - predlžovanie trvanlivosti potravín
4.Mikrobiológia produktov a potravín rastlinného pôvodu
5.Mikrobiológia produktov a potravín živočíšneho...
prečítať celé
- Mohlo by Vás taktiež zaujať
- Ďalšie knihy autora
- Ďalší tovar nakladateľa
- Naposledy prezreté
Podobní autoři
Kniha návstěv
Overené príspevky sú takto označené, ostatné sú neoverené.
Milka Murinova
Dobry den.Chcem sa opytat na tu deku Jerry Fabrics Deka mikroflanel soft Vinnova 150/200.Aka to je deka.Ci sa to hodi.Na prikritie gauca.Dakujem.A ci mate aj väcsi rozmer 170/200. Vdaka
Peter Jurasko
Súper ešte stema ne sklamali
Kristína
Overený príspevok
Moja najobľúbenejšia stránka na objednávania knih. Velky vyber, super ceny, 99% objednávok veľmi rýchlo vybavená. Keď knihy, tak len odtiaľto
Jano
Overený príspevok
Zakúpil som si sat.zosilova.Bol som skôr skepicky,už som neveril ze mi nieco v mojom probléme zo signálom pomôze.Ale zakúpený zosilovač u Vás problém k spokojnosti vyriešil.Prijatelna cena a rýchlosť doručenia sú už len bombonikom mojej spokojnosti z Vašim obchodom.
Veronika
Overený príspevok
Som veľmi spokojná s tovarom ,úžasná komunikácia s obchodom a snaha o ochranu nášho životného prostredia ❤️ ďakujeme
Stanislav
Som spokojný s tovarom i keď dlžka dodania je pomerne dlhá.Už som toho nakúpill viac a určite ešte budem.
Diana
Overený príspevok
Som Vášmu obchodu verná už roky. Zaručene najlepšie ceny a široký výber. Ďakujem!
Eva
Dakujem za vase vyrobky ,som velmi spokojna
Daniela
Overený príspevok
Už mám odtiaľto pár vecí za výhodnú cenu.Som spokojná.
Pavol
Overený príspevok
Nakupujem pravidelne, moja veľká spokojnosť.Ďakujem.
Veľkoobchodná spolupráca
Ak máte zaujímavý sortiment, neváhajte nás osloviť. Ponúkame zaujímavé odbery, rýchle platby a rešpektuplnú spoluprácu.
velkoobchody@megaknihy.sk

 Kontakt
Kontakt
 Účet
Účet